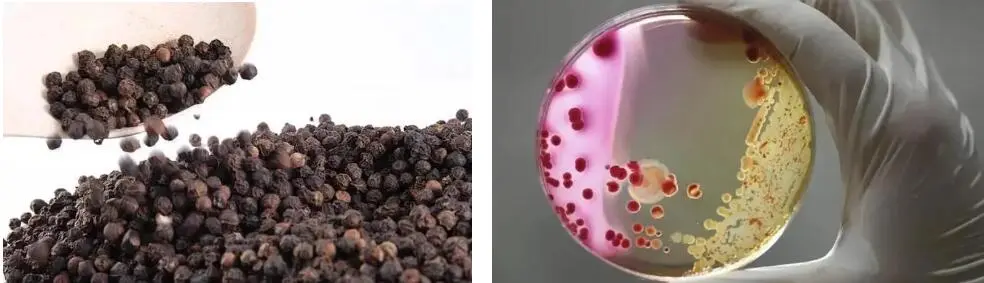
TURMERIC ROOT EXTRACT POWDER TURMERIC ROOT EXTRACT POWDER

Turmeric root extract powder has collected critical consideration lately because of its potential medical advantages. In this article, we will delve into the recommended dosage guidelines for it to address various health concerns. Understanding the appropriate dosage is crucial for maximizing the therapeutic effects while minimizing potential risks.
Understanding Turmeric Root Extract Powder
Turmeric, logically known as Curcuma longa, is a blooming plant having a place with the ginger family, local to the Indian subcontinent. It has been utilized for a really long time in conventional medication for its restorative properties.
Turmeric root separate powder contains bioactive mixtures, with curcumin being the most noticeable. Curcumin is known for its cell reinforcement, calming, and expected anticancer properties, making turmeric a famous regular cure.
Curcumin is the vitally dynamic fixing in turmeric root remove powder, answerable for its restorative impacts. It exerts its benefits through various molecular pathways, making it a promising candidate for combating various health issues.

Daily dosage for overall health maintenance:To maintain overall health, a daily dosage of the powder is recommended. The commonplace measurement goes from 500 mg to 2,000 mg each day, contingent upon individual factors like age, weight, and wellbeing status.
Individual factors like age, weight, and existing medical issue assume a critical part in deciding the fitting measurement of turmeric root separate powder. It is fitting to counsel a medical care proficient to decide the ideal measurements for every person.
Irritation and Joint Health:For aggravation and joint wellbeing, higher dosages of turmeric root remove powder might be required. Measurements going from 1,000 mg to 2,500 mg each day have been prescribed to reduce side effects and work on joint capability.
Digestive Health:In addressing digestive health issues such as indigestion or irritable bowel syndrome (IBS), a moderate dosage of the powder, typically around 500 mg to 1,500 mg per day, may be beneficial.
Heart Health:The powder may contribute to heart health by reducing cholesterol levels and improving blood circulation. Dosages ranging from 500 mg to 2,000 mg per day have been suggested to support cardiovascular function.
Brain Health and Cognitive Function:For brain health and cognitive function, higher doses of the powder may be advantageous. Dosages of 1,000 mg to 2,000 mg per day have been recommended to potentially enhance memory and cognitive abilities.
Skin Health:Turmeric root extract powder may offer benefits for skin health, particularly in managing conditions like acne or eczema. Daily dosages of 500 mg to 1,500 mg may help improve skin appearance and alleviate symptoms of certain skin disorders.
Other potential health concerns:The powder has been studied for its potential benefits in various other health concerns, including cancer prevention, diabetes management, and immune system support. Dosages may vary depending on the specific condition and individual factors.

Importance of bioavailability:Bioavailability refers to the extent and rate at which a substance is absorbed into the bloodstream. Enhancing the bioavailability of it is crucial for optimizing its therapeutic effects.
Enhancing absorption with black pepper or piperine:Black pepper or its active compound piperine has been shown to enhance the absorption of curcumin, the active compound in turmeric. Combining it with black pepper or piperine may significantly increase its bioavailability.
Other methods to increase bioavailability:Other methods such as consuming it with fats or incorporating it into liposomal formulations may also enhance its bioavailability, ensuring maximum absorption and efficacy.
Potential interactions with medications:The powder may interact with certain medications, including blood thinners and drugs metabolized by the liver. It is essential to consult a healthcare professional before incorporating turmeric into your regimen, especially if you are taking medications.
Allergic reactions:While rare, allergic reactions to it may occur, particularly in individuals allergic to ginger or yellow food coloring. Symptoms may include rash, itching, or difficulty breathing.
Side effects from high doses:Consuming high doses of it may lead to gastrointestinal issues such as nausea, diarrhea, or indigestion. It is advisable to adhere to recommended dosage guidelines to minimize the risk of adverse effects.

Optimal dosage of the powder varies depending on individual factors and specific health concerns. It is essential to consult a healthcare professional to determine the appropriate dosage for maximum health benefits.
Consulting healthcare professionals is paramount to ensure safe and effective use of the powder, especially when addressing specific health concerns or combining it with medications.
Further research is warranted to explore the full potential of the powder in addressing various health concerns and to elucidate optimal dosage guidelines for specific populations and conditions.
Contact us
Are you looking for a reliable supplier of turmeric root extract powder? Look no further! We are a professional manufacturer with a GMP-certified factory, extensive inventory, and comprehensive certifications. We support OEM services, ensuring quick delivery and secure packaging. Contact us at sales@greenherbbt.com to collaborate and access top-quality it for your needs.